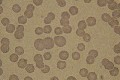

|
 |
 |
1.2. Les anémies faiblement régénératives (anémies microcytaires hypochromes).
1.2.1. Les anémies ferriprives.
Elle apparaisent à la suite d'une carence en fer prolongée, souvent liées à des hémorragies ou des spoliations chroniques.
Diagnostic :
Traitement :
1.2.2. Les anémies des maladies inflammatoires.
Les signes d'anémie et de microcytose sont plus modérés que dans le cas précédent. L'anémie est due à une ségrégation du fer dans les macrophages. En conséquence :
1.2.3. Les anémies par carence en vitamine B6.
Elles sont très rares et concernent principalement le chat. Dans ce cas il y aune anémie microcytaire hypochrome et une sidérémie élevée. Des sidérocytes (hématies avec des inclusions colorées au Perls) sont présents dans le sang.
1.2.4. Les anémies des shunts porto-systémiques.
Environ 2/3 des chiens atteints de shunt porto-systémique présentent une microcytose associée à une anémie modérée.
1.3. Les anémies arégénératives
1.3.1. Les anémies arégénératives macrocytaires normochromes.
1.3.1.1 Les carences en Vitamine B12 et folates
Cette forme d'anémie, fréquente chez l'homme semble très rare chez les carnivores. De même, lorsqu'il existe une carence en vitamine B12 ou en folates, la macrocytose est rarement effective chez les carnivores. En revanche des modifications mégaloblastiques sont observables dans la moelle osseuse. Une neutropénie avec hypersegmentation existe chez le chien, mais pas chez le chat.
Il existe chez le schnauzer géant un déficit en récépteurs de cobalamine au niveau des entérocytes qui est responsable de cette forme d'anémie, mais aussi de retard de croissance et de troubles nerveux. La supplémentation en vitamine B12 de ces chiens doit se faire, bien évidemment, par voie parentérale.
Les infections par le FeLV ou les états préleucémiques sont responsables d'une macrocytose modérée qui se traduit par une anisocytose sur le frottis. Les réticulocytes sont absents et parfois des érythroblastes sont visibles. Ces états fugaces précèdent souvent les anémies arégénératives.
|
Les macrocytes observés ne sont pas des réticulocytes, qui sont par ailleurs absents chez ce chat présentant un envahissement médullaire. cliquer sur la photo pour l'agrandir |
1.3.2. Les macrocytoses non anémiantes.
1.3.2.1 La macrocytose des Greyhounds.
Elle est physiologique et elle semble compenser une durée de vie plus courte des hématies (55 jours). Le VGM et de 81 fmol en moyenne et la TCMH est également plus élevée que dans les autres races.
1.3.2.2 La macrocytose des Caniches.
Résultant d'une dyscrasie médullaire, elle est également asymptômatique. Cette macrocytose (VGM=94 fmol) est associée à :
1.3.2.3 La stomatocytose des Alaskan Malamutes.
Le VGM est de l'ordre de 93 fmol et les hématies présentent une pâleur centrale allongée. Il existe une forme anémiante de cette maladie héréditaire qui touche les schnauzer nains.

1.3.3. Les aplasies médullaires.
1.3.3.1. Les aplasies érythroïdes isolées.
1.3.3.1.1. Les causes hormonales
Les causes hormonales sont assez fréquentes :
1.3.3.1.2. Les causes immunitaires
Chez le chien, certaines anémies hémolytiques sont compliquées d'une destruction à médiation immune des précursseurs érythroïdes. Dans les formes aiguës, les signes hématologiques sont ceux d'une AHI sans la réticulocytose. Le test de coombs direct est positif dans seulement 50% des cas. Dans les formes chroniques, en revanche, le diagnostic nécessite un myélogramme (Cf. myélogramme de l'aplasie érythroïde). Le pronostic est bon lorsque l'on instaure une corticothérapie à dose immunosuppressive précoce. Des formes similaires sont également décrites chez le chat.
L'utilisation de l'érythropoïétine recombinante humaine dans le traitement de l'anémie arégénérative chez les carnivores aboutit à une alloimmunisation et une aplasie des précursseurs érythroïdes au bout de 4 à 16 semaines de traitement.
1.3.3.1.3. Les causes infectieuses
Les parvovirus sont capables d'infecter les précurseurs érythroïdes et de provoquer une aplasie érythroïde. Cependant à la différence de l'homme, elles sont le plus souvent associées à une aplasie des autres lignées chez les carnivores (Cf. myélogramme de l'aplasie médullaire à parvovirus). Certains cas d'aplasie érythroïde pure ont été rapportés chez le chien après une vaccination avec un vaccin parvovirus vivant (Dodds WJ, 1983).
Chez le chaton une forme rare d'infection par le FeLV-C provoque une déplétion sévère et mortelle des îlots érythroïdes.
1.3.3.2 Les aplasies médullaires combinées.
1.3.3.2.1. Les causes iatrogènes.
La plus importante est l'aplasie due aux oestrogènes qui peuvent aussi être d'origine endogène comme dans le cas du sertolinome du chien ou de l'oestrus prolongé de la furette.
Des aplasies occasionnelles peuvent apparaître avec:
1.3.3.2.2. Les causes infectieuses
Il s'agit essentiellement des parvovirus, du FeLV et de l'erhlichiose canine qui seront abordés dans l'étude des leucocytes.
1.3.3.2.3. Les causes tumorales
Ces pathologies seront abordées plus en détail dans l'étude des leucocytes et dans l'atlas de myélogrammes.
Il peut s'agir de la prolifération d'une lignée médullaire au détriment des autres. Souvent au stade de l'aplasie, les cellules sont présentes dans le sang (leucémie).
Certaines tumeurs peuvent envahir la moelle osseuse responsable d'un étouffement médullaire. Dans ce cas des précursseurs hématopoïetiques sont retrouvés dans la circulation.
Les myélodysplasies constituent un défaut de maturation de certaines lignées médullaires. Elles peuvent être d'origines très diverses mais elles caractérisent souvent un état pré-leucémique.
Certaines leucémies et certains cancers peuvent provoquer une myelofibrose (Cf. Myélogramme)
Chien |
Chat |
|
| Normes | <8500000 |
<10000000 |
| Polyglobulie sévère | >11000000 |
>14000000 |
Ne seront abordées que les polyglobulies absolues, les polyglobulies relatives étant des états transitoires liés à la déshydratation ou à la contraction splénique. Dans les deux cas une leucocytose sans bascule à gauche est également présente.
Les polyglobulies sévères se manifestent par la clinique suivante :
 |
Organigramme indicatif pour la détermination de l'étiologie des polyglobulies. cliquer sur l'image pour l'agrandir |
Elles sont associées à un taux d'érythropoïétine (EPO) faible. Elles évoluent en général sur un mode chronique. Elles peuvent être confondues avec la polycythémia vera qui implique d'autres lignées médullaires. Chez les carnivores, à la différence de l'Homme, il est très rare que l'ensemble des lignées médullaires prolifèrent lors de polycythémia vera.
Le traitement est symptomatique par la pratique de saignées de 10 à 20 ml / Kg. Une chimiothérapie à base d'hydroxyurée (HydreaND) peut être entreprise à la dose initiale de 30mg / Kg pendant 7-10 jours. En entretien, la dose peut être diminuée de moitié et administrée de manière discontinue.
Leur prépondérance par rapport aux polyglobulies primitives varie selon les études. En France elles seraient plus fréquentes, mais le contraire est constaté aux Etats-Unis.
Les étiologies sont diverses.
L'altitude supérieure à 1800 m peut provoquer une polyglobulie d'adaptation. Plus souvent ce sont des causes pathologiques qui se manifestent par de la dyspnée et plus rarement par de la cyanose :
2.2.3. Les tumeurs extra-rénales.